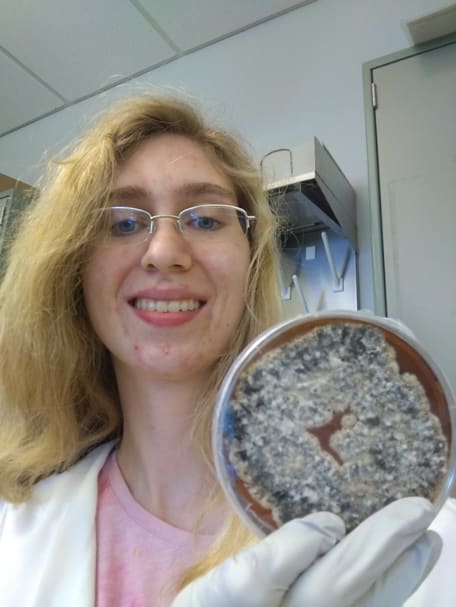

This project has ended. If you are interested in supporting Institute for Student Research & Creative Activity, please contact Andi Sharp at sharpa5@nku.edu or (859) 572-7530. Thank you!
Thank you for your support! We are in the final week of our campaign.
This update comes from our office the day after Celebration - it was a fantastic event with more than 400 students participating! Check out some of the pictures on our social media pages.
We wanted to share an experience of one of our students to show the impact that your donations will have on our students' lives. Dakota Langhals is a junior economics and mathematics major who is interested in public policy research. This summer with his ISRCA summer fellowship, he worked with Dr. Abdullah Al-Bahrani to measure the effect that predatory lending laws have on mortgage prices and closure rates. His research involved conducting an extensive literature review on different kinds of predatory lending as well as legislative responses to them, identification of a model that estimates the impact of legislation on mortgage price and closure rate, and synthesizing that information into a completed research paper. This project was presented at the Kentucky Economic Association's annual conference in October, where Dakota received the 2018 Winner of Best Undergraduate Paper for this work. Dakota plans to pursue a PhD in economics after he graduates and hopes to contribute to discussions around policy issues such as welfare, healthcare, education, transportation, and housing.
Just a few days left to show your support! – impact.nku.edu/ISRCA2

We are halfway through our campaign!
We are 18% to goal! We are so thankful for the support from our faculty, students, alumni, and friends. Your donations will impact the education of students like Neha Srivatsa and Ashley Wentworth.
Neha is a psychology major who received an ISRCA summer fellowship last year. In a series of three experiments, Neha examined how students' fear of failure influences their responsiveness to two forms of praise: ability praise and effort praise. She tested these to determine whether these types of praises would be able to complete difficult tasks. Working the Dr. Kalif Vaugh, Neha conducted an experiment nationwide using MTurk and hopes to create a publishable manuscript out of the results.
Ashely is a senior biological science major, who plans to become a microbiologist. With her ISRCA summer fellowship, she worked with Drs. Alan Cohen and Joe Mester on a project pertaining to susceptibility of various environmental fungi of ultraviolet light (UV). During the culturing and identification of unique fungi, her fascination with fungi peaked. She discovered that this project ties into the industrial, medical, and environmental fields of microbiology. This research will lead to other novel projects involving other microorganisms.
.
We have had an excellent start to our campaign, thank you to our donors! But we still need your support – please share this message with others who might be interested in supporting student research and creative activity at NKU and direct them to this link impact.nku.edu/ISRCA2
Off to a great start!
Thank you for your support of this campaign, we have already raised 10% of our goal.
Your donations make a difference in our students’ lives. One student that received a summer fellowship specifically from last year’s impact campaign was Isaiah Reaves. Isaiah is in NKU's drama department. This past summer, Isaiah, along with other NKU students and alum, mounted a production of a play he wrote titled "The Blackface Project" at the Cincinnati Fringe Festival. The play was based on research Isaiah conducted on the life of Broadway's first black star, Bert Williams. The show went on to become the third highest grossing production in the festival, as well as a Citybeat Critic's Pick. Isaiah received an ISRCA summer fellowship to fund his production and paid for his time as well. During the summer Isaiah was also selected to participate in a highly competitive playwright seminar. Isaiah worked with Dr. Daryl Harris on his project and presented his research in our office this past fall.
With your help we can fund more students like Isaiah! We have had an excellent start to our campaign, thank you to our donors! But we still need your support – please share this message with others who might be interested in supporting student research and creative activity at NKU and direct them to this link: impact.nku.edu/ISRCA2


$50
Give $50
A donation of $50 could print a poster for a student presentation for our Celebration of Student Research and Creativity.
$100
Give $100
A donation of $100 could pay for registration fees for a student to attend a conference to present their research.
$250
Give $250
A donation of $250 could pay for travel to a conference for a student to present their research.
$500
Give $500
A donation of $500 could pay for supplies for a student research project.
$1,000
Give $1,000
A donation of $1,000 could fund a student's research for a summer.